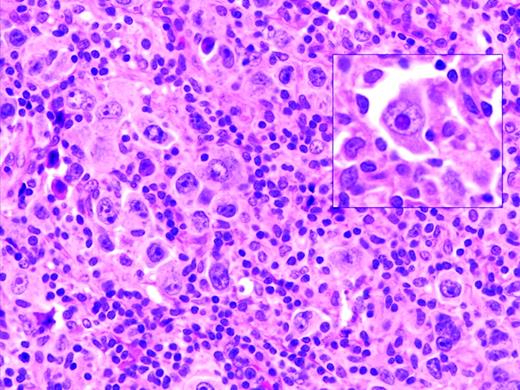
Figure 1. EBV-positive DLBCL of the elderly. Large lymphoid cells, some with prominent inclusion-like nucleoli (inset) are seen in a background of lymphocytes and histiocytes. Large lymphoid cells are EBV positive with EBER in situ hybridization (not shown).

Abstract
Aggressive B-cell lymphomas are clinically and pathologically diverse and reflect multiple pathways of transformation. The 2008 World Health Organization (WHO) classification reflects this complexity with the addition of several new entities and variants. Whereas MYC translocations have long been associated with Burkitt lymphoma (BL), deregulation of MYC has been shown to occur in other aggressive B-cell lymphomas, most often as a secondary event. Lymphomas with translocations of both MYC and BCL2 are highly aggressive tumors, with a high failure rate with most treatment protocols. These “double-hit” lymphomas are now separately delineated in the WHO classification as B-cell lymphoma, unclassifiable, with features intermediate between diffuse large B-cell lymphoma (DLBCL) and BL. A MYC translocation is also found uncommonly in DLBCL, but the clinical consequences of this in the absence of a double hit are not yet fully delineated. Most recently, MYC translocations have been identified as a common secondary event in plasma cell neoplasms, seen in approximately 50% of plasmablastic lymphoma. Another area that has received recent attention is the spectrum of EBV-driven B-cell proliferations in patients without iatrogenic or congenital immunosuppression; most of these occur in patients of advanced age and include the EBV-positive large B-cell lymphomas of the elderly.
Introduction
The World Health Organization (WHO) classification lists nearly 100 different variants of lymphoid malignancy.1 This tremendous diversity of lymphoid neoplasms reflects the diversity of the immune system, both in terms of stage of differentiation and functional repertoire. The relationship between normal lymphoid cells and lymphoid neoplasms has been best appreciated in low-grade B-cell lymphomas and leukemias, but for a long time, most aggressive B-cell lymphomas were lumped together under diffuse large B-cell lymphoma (DLBCL). More recently, the complexity of aggressive B-cell lymphomas is being more clearly resolved, and the 2008 WHO classification lists a large number of aggressive B-cell neoplasms beyond DLBCL not otherwise specified (DLBCL, NOS; Table 1).
Like most other tumors, lymphomas are typically classified according to their presumed normal counterpart. Therefore, some of the subtypes of aggressive B-cell lymphoma reflect different cellular origins, such as mature B cells versus more differentiated plasma cells. However, whereas differentiation schemes provide useful conceptual frameworks for understanding lymphomas, some well-defined lymphoma subtypes, such as intravascular large B-cell lymphoma, lack obvious normal counterparts. In other diseases, there may be evidence of maturation along a differentiation pathway within the clone or even lineage plasticity. In addition, pathways of transformation are becoming more important in defining distinct disease entities as we strive for a pathogenetically driven classification system. Several aggressive B-cell lymphomas are defined primarily on either specific genetic aberrations, such as ALK-positive large B-cell lymphoma, or viruses involved in B-cell transformation, such as primary effusion lymphoma. This review emphasizes some of the entities to be recognized more recently, as well as areas of diagnostic challenge, such as the interface between DLBCL and Burkitt lymphoma (BL).
DLBCL, NOS
DLBCL, NOS is certainly the most common aggressive B-cell lymphoma and the most common type of lymphoma on a worldwide basis. This diagnosis is used both for primary DLBCL and for cases of transformation from a low-grade B-cell malignancy, such as follicular lymphoma or chronic lymphocytic leukemia, the so-called Richter's transformation. DLBCL, NOS may present in lymph nodes or in extranodal sites. Frequent extranodal sites of involvement include the bone, skin, thyroid, gastrointestinal tract, and lung. Acknowledging the heterogeneity of DLBCL, NOS, the emphasis in recent years has focused on pathways of transformation and molecular alterations as a way to further subclassify these tumors into biologically relevant subgroups.2–3 The most common genetic aberrations in DLBCL, NOS involve the BCL6 gene and are seen in 30% of cases.4 Translocations involving MYC may be seen in up to 10% of cases,5–6 and BCL2 translocations are frequent in lymphomas of the germinal-center B (GCB)–cell subgroup.7
High-throughput technology to establish the RNA gene-expression profile (GEP) of DLBCLs has been a powerful tool, in part facilitated by the high content of tumor cells in most lesions, and absence of a significant inflammatory background. Staudt and colleagues showed that at least 2 major types of DLBCL could be identified, resembling either GCB cells or activated B cells (ABCs).8 GCB DLBCLs have a better prognosis irrespective of other clinical factors. The categories of ABC and GCB DLBCL, originally formulated based on a “cell-of-origin” model, have more recently been shown to harbor different pathways of cellular transformation and oncogenesis.9–10 Changes in therapy have also altered the impact of the cell-of-origin designation, with some studies showing less impact in the rituximab era.11
Immunohistochemical profiles have been proposed as surrogates of the GEP, and whereas the correspondence is not exact, similar prognostic correlations can be drawn with immunohistochemically defined groups.12–14 The classic Hans algorithm used BCL6, CD10, and MUM-1/IRF4, but the panel has been expanded in newer iterations, with greater predictability of outcome.14–15 The degree to which the immunohistochemically defined subtype, ABC versus GCB, is correlated with the GEP has been variable.14,16 A recent study showed the continued relevance of the GEP in a clinical trial using rituximab plus chemotherapy, but none of the immunohistochemical algorithms used could reproduce this result.17 This lack of concordance may be explained in part by problems in reproducibility among different laboratories in performing and scoring the immunohistochemical studies.18–19
In addition, there has been interest over the years in identifying morphologic features that might be prognostically important. Historical studies suggested that tumors composed predominantly of centroblasts had a better prognosis than those composed predominantly of immunoblasts.20 Compared with the GEP, the immunoblastic category is enriched for cases with an ABC profile, whereas purely centroblastic neoplasms are more often GCB.8 However, the differences have not been reproducible when applied to a broad spectrum of tumors, possibly reflecting diverse criteria for the designation of a lymphoma as immunoblastic. The use of cytological criteria was recently resurrected by Ott et al,21 who found that immunoblastic morphology was highly significant in predicting an adverse outcome. However, in a trial of 949 patients, only 7.4% were classified as immunoblastic. Whereas the investigators were able to apply very stringent criteria to identify a prognostically relevant subset, because of the rarity of these lesions, the utility of this approach in general practice is limited.
CD5-positive DLBCL has been suggested in some studies, mainly from Japan, to have distinctive clinical features.22 These patients are often older and present with bulky retroperitoneal disease. These cases arise de novo, and have no relation to chronic lymphocytic leukemia or mantle cell lymphoma, which also express CD5. CD5-positive DLBCL is not thought to be a specific disease entity, but rather its aggressiveness may reflect CD5 as an activation antigen.
DLBCL subtypes in specific anatomic sites
Several variants or subtypes of DLBCL have been segregated out in the WHO classification because of distinctive clinical presentations and features that dictate different clinical management. These include primary DLBCL of the CNS; primary cutaneous DLBCL, leg type; and intravascular large B-cell lymphoma. Primary CNS DLBCL also includes those cases presenting with intraocular disease, and patients with intraocular disease have a high risk of spread to the CNS. GEP studies have demonstrated some unique features in primary CNS tumors.23–25 However, a consistent pattern as to the presence of ABC or GCB has not emerged. It is interesting that there appears to be a link between primary CNS DLBCL and DLBCL presenting in the testis, perhaps because both are immunoprivileged sites.26–27
Cutaneous lymphomas differ in many respects from lymphomas in other sites, and often have a better prognosis.28 Primary cutaneous follicle center lymphomas may be composed predominantly of large B cells in some cases, but nevertheless have an indolent clinical course and are not considered a form of DLBCL. In contrast, the entity primary cutaneous DLBCL, leg-type is clinically more aggressive,28 resembling the activated B-cell type of nodal DLBCL as shown by GEP and immunophenotype.29 As with nodal DLBCL, BCL-2 expression is an adverse prognostic factor and is correlated with the ABC GEP.30 In contrast to primary cutaneous follicle center lymphomas, patients with DLBLC, leg type usually require chemotherapy for clinical management.
Intravascular large B-cell lymphoma is considered a separate disease entity and is a rare form of DLBCL characterized by the presence of large B cells only in the lumens of small vessels, particularly capillaries.31 Lymph node involvement is rare, and the tumor presents in extranodal sites, most readily diagnosed in the skin.28 Neurological symptoms associated with plugging of small vessels in the CNS are common. The disease is often not diagnosed until autopsy because of the lack of definitive radiological or clinical evidence of disease and diverse symptomatology. Patients presenting with cutaneous disease appear to have a somewhat better prognosis, probably because of early detection. Using immunophenotyping as a surrogate for the GEP, the majority of intravascular DLBCL cases have an ABC phenotype.32 Many cases of intravascular DLBCL also express CD5. In the cases reported from Japan, the disease is often associated with a hemophagocytic syndrome, a feature seen less often in Western cases.32
T/HRLBCL
T-cell/histiocyte-rich large B-cell lymphoma (T/HRLBCL) is a morphological variant of DLBCL, but one with many distinctive clinical features.33–34 It has an aggressive clinical behavior, and often presents with advanced stage, splenomegaly, and BM involvement. The micronodular pattern seen in the spleen can be diagnostically challenging to the inexperienced observer. Recent studies have focused on the mechanisms of recruitment of inflammatory cells and the relationship to the microenvironment.35 Some cases appear related to nodular lymphocyte predominant Hodgkin lymphoma (NLPHL), with the neoplastic cells being epithelial membrane antigen–positive and having an lymphocyte predominant–like morphology.36 In addition, NLPHL may progress to a process indistinguishable from de novo T/HRLBCL. The relationship between primary and secondary T/HRLBCL is not fully resolved, and in some instances the distinction between NLPHL and T/HRLBCL can be problematic in primary biopsy specimens. Features that favor T/HRLBCL include the absence of small B cells or evidence of a follicular structure such as the absence of follicular dendritic cells. Despite the abundance of T cells in T/HRLBCL, well-formed T-cell rosettes are usually absent. The clinical picture is important because T/HRLBCL very rarely presents with localized stage I disease. Other cases with an overlapping morphological appearance may be composed of EBV-positive cells resembling Hodgkin/ Reed-Sternberg (HRS)–like cells in a background rich in T cells.37 Whereas once considered a subtype of T/HRLBCL, EBV-positive cases are now included within EBV-positive large B-cell lymphoma.
EBV-positive DLBCLs
Oyama et al described EBV-positive B-cell lymphoproliferative disorders in elderly Japanese patients,38 and this lesion is now recognized as a provisional entity in the WHO classification as EBV-positive DLBCL of the elderly. It is defined as a histologically malignant polymorphic or monomorphic B-cell lymphoproliferation in patients who are generally over the age of 50 without any known immunodeficiency or prior lymphoma. The clinical behavior is aggressive, with frequent extranodal presentation and overall poor prognosis. Some cases show morphological overlap with classical Hodgkin lymphoma (cHL), also encountered in the elderly, but said to have a better prognosis.39 The lesion is thought be related to immunosenescence, the natural decay of the immune system as a consequence of aging.38 A recent large series of patients from the Western world showed overall similar clinical and pathological features, with a median age at presentation of 75 and an aggressive clinical course40 (Figure 1). However, despite the propensity to present at advanced age, identical lesions can be seen more rarely in younger patients, sometimes occurring close to the time of primary EBV infection.
EBV-positive DLBCL of the elderly. Large lymphoid cells, some with prominent inclusion-like nucleoli (inset) are seen in a background of lymphocytes and histiocytes. Large lymphoid cells are EBV positive with EBER in situ hybridization (not shown).
EBV-positive DLBCL of the elderly. Large lymphoid cells, some with prominent inclusion-like nucleoli (inset) are seen in a background of lymphocytes and histiocytes. Large lymphoid cells are EBV positive with EBER in situ hybridization (not shown).
Dojcinov et al also described EBV-driven proliferations, termed mucocutaneous ulcers, that present in cutaneous or mucosal sites and are histologically alarming, but have a much more indolent and often self-limited clinical course.40–41 The cells in mucocutaneous ulcers often have an immunophenotype resembling cHL, with expression of CD30, CD15, and variable CD20. Several of the patients with a proposed diagnosis of cHL reported by Asano et al had extranodal disease involving gastrointestinal tract (n = 4), skin (n = 2), and lung (n = 2).39 Great caution should be exercised in making a diagnosis of cHL in extranodal sites.
Selected EBV-positive B-cell lymphoproliferations may show overlapping histological features with cHL. Historically, cells resembling HRS-cells have been described in many EBV-associated conditions ranging from infectious mononucleosis42 to methotrexate-associated lymphoproliferative disease.43 The correct diagnosis requires integration of clinical and pathological features, with the immunophenotype interpreted in context. These atypical EBV-positive proliferations are not included in the new category of “B-cell lymphoma, unclassifiable, with features intermediate between DLBCL and cHL” reviewed below.1
Another distinctive form of EBV-positive DLBCL is DLBCL associated with chronic inflammation. This lesion was first recognized in patients with longstanding chronic pyothorax.44 However, an identical process may be seen in areas of chronic inflammation affecting body cavities or restricted spaces such as joints.45 The EBV-positive tumors have a latency III pattern of antigenic expression and in general have a good prognosis.46
PMBL
Based on its unique clinical and molecular features, mediastinal (thymic) large B-cell lymphoma (PMBL) has been recognized for several years as a distinct entity,47–50 although cytologically it resembles many other DLBCL types. It is common in adolescents and young adults, with a median age at presentation in the fourth decade, but also can present in the pediatric age group.51 The tumor is thought to be derived from medullary B cells within the thymus gland. The cells express CD20 and CD79a, but do not express surface immunoglobulin. CD30 is often positive, and in some cases, the distinction from nodular sclerosis cHL can be difficult—the so-called “gray zone lymphomas” (GZLs).52 Pivotal studies showed a GEP differing from other DLBCL and resembling cHL, with up-regulation of the NFκB pathway.53–54 A detailed discussion of PMBL is beyond the scope of this review.
DLBCLs with a plasmablastic phenotype
ALK-positive large B-cell lymphoma is one of a series of aggressive B-cell neoplasms in which the neoplastic cells resemble transformed cells with a terminally differentiated B-cell/plasma-cell phenotype.55 ALK-positive large B-cell lymphoma was one of the first to be recognized as having a unique molecular pathogenesis that is associated with translocations targeting the ALK gene. The t(2;17) involving ALK and clathrin is the most common of these, but the classical t(2;5) of anaplastic large-cell lymphoma can also be seen. Most cases express the IgA heavy chain, but there is often a down-regulation of other B-cell–associated antigens. In contrast to anaplastic large-cell lymphoma, in ALK-positive large B-cell lymphoma, CD30 is negative. The disease most often presents in adults, but pediatric cases have been reported.56–57 The prognosis is poor.
Plasmablastic lymphoma (PBL) is most commonly associated with the oral cavity and is usually diagnosed in the setting of HIV infection.58 However, PBL can occur in other settings of decreased immune surveillance, such as advanced age.59 Nearly all cases of PBL are EBV positive, and typically present in extranodal sites, often with a mucosal or cutaneous localization. The tumor cells have immunoblastic or plasmablastic features, and typically do not show evidence of ongoing plasmacytic differentiation. Recent studies have shown a high incidence of MYC translocations in PBL,60–61 and similar genetic anomalies in plasma cell myeloma undergoing blastic transformation provide evidence for a link between myeloma and PBL.62
Primary effusion lymphoma (PEL) is a novel lymphoproliferative disorder associated with human herpesvirus 8 (HHV-8) infection.63 Most PEL patients are coinfected with EBV, and many are HIV seropositive. The disease also occurs in areas with high seroprevalence for HHV-8 infection such as the Mediterranean, and usually in elderly males.64 Many affected patients also have a history of Kaposi sarcoma and, less commonly, multicentric Castleman disease.65 The most common sites of involvement are the pleural, pericardial and peritoneal cavities. Some cases may present with tumor masses involving the gastrointestinal tract, soft tissue and other extranodal sites, termed extracavitary PEL.66
The cells exhibit usually have plasmablastic or immunoblastic morphology, with some cells having more anaplastic morphology. The disease should be distinguished from pyothorax-associated DLBCL, which usually presents with a pleural mass lesion, and is EBV-positive, but HHV-8-negative. The cells have a plasmablastic phenotype, with loss of mature B-cell surface markers. Interestingly, aberrant cytoplasmic CD3 expression has been reported, something that has been encountered in other EBV-transformed malignancies, and is a potential diagnostic pitfall as conventional B-cell markers are usually lost.46,67 Immunohistochemistry for the HHV-8/KSHV-associated latent protein (LANA) is most useful diagnostically. Interestingly, stabilization of MYC also has been implicated in pathogenesis of PEL through unknown mechanisms.68–69
A related disorder is large B-cell lymphoma arising in HHV-8 associated multicentric Castleman disease (MCD).70 This process represents an expansion of immunoblastic cells within a lymph node in the setting of MCD. Activation of the IL-6–signaling pathway mediates many of the clinical stigmata in MCD patients.71 The cells express IgMλ, but may be polyclonal at the genetic level. Variations on this theme with unusual lymphoid proliferations coinfected with both EBV and HHV-8 have been described more recently.72
BL
BL is most common in children and accounts for up to one-third of all pediatric lymphomas in the United States. The WHO classification includes 3 clinical variants of BL that are associated with different clinical settings: endemic BL, sporadic BL, and AIDS-associated BL. These clinical variants are similar histologically, but do show variation in the association with EBV. EBV is closely linked to BL in endemic regions but is less frequently seen (15%-20%) in European and North-American cases. In other regions characterized by low socioeconomic status and EBV infection at an early age, BL is often EBV positive, in the range of 50%-70%. An intermediate EBV prevalence is seen in HIV-associated BL. These data support the concept the EBV is a cofactor for the development of BL.73 There is evidence in some settings that EBV may contribute to BL pathogenesis by blocking apoptosis.74–75 EBV-positive BL has a latency I phenotype, with limited expression of EBV-associated proteins. The tumor cells are generally positive for EBNA1 but negative for LMP and most other EBV-associated antigens.
Cytologically, BL is monomorphic, composed of uniform cells of modern size with minimal cytological variation. The cells are medium in size with round nuclei, moderately clumped chromatin, and multiple (2-5) basophilic nucleoli. The cytoplasm is deeply basophilic. These cells contain cytoplasmic lipid vacuoles, which are probably a manifestation of the high rate of proliferation and of spontaneous cell death. The “starry sky” pattern characteristic of BL is a manifestation of the numerous benign macrophages that have ingested karyorrhectic or apoptotic tumor cells. BL has a mature B-cell phenotype, with surface Ig of the IgM class. CD10 is positive in nearly all cases, and the typical absence of BCL-2 expression is helpful in ruling out “double-hit” lymphomas with dual translocations affecting MYC and BCL2.
Translocations involving the MYC oncogene are the molecular hallmark of BL, and are seen in virtually 100% of cases. Most cases involve the IGH@ gene on chromosome 14. Less commonly, the light-chain genes on chromosomes 2 and 22 are involved in the translocation. The development of FISH assays readily performed in paraffin sections has facilitated the recognition of MYC translocations for routine diagnosis, even when viable cells are not available for complete karyotypic studies.76 In BL, the MYC translocation is considered a primary event, and the remainder of the karyotype usually shows few abnormalities and is therefore called “MYC simple.” This is in contrast to lymphomas in which the MYC translocation occurs as a secondary event, which are called “MYC complex.” More recently, studies have suggested that immunohistochemical studies for the MYC protein may be useful in detecting lymphomas harboring a MYC translocation.77 The majority of cases with a strong nuclear signal carry the translocation, whereas other patterns of staining are of uncertain significance (Figure 2).
BL with immunohistochemistry for MYC protein. (Left) Section showing BL associated with an epithelioid granulomatous reaction. (Right) Same case stained for MYC protein; tumor cells show strong nuclear positivity, whereas epithelioid histiocytes are negative for MYC. Strong nuclear staining is typical of BL, but may be seen in some cases of DLBCL with a high proliferative rate.
BL with immunohistochemistry for MYC protein. (Left) Section showing BL associated with an epithelioid granulomatous reaction. (Right) Same case stained for MYC protein; tumor cells show strong nuclear positivity, whereas epithelioid histiocytes are negative for MYC. Strong nuclear staining is typical of BL, but may be seen in some cases of DLBCL with a high proliferative rate.
B-UNC/BL/DLBCL
The distinction of BL from morphologically similar aggressive B-cell lymphomas has been problematic for pathologists and clinicians. For years, a variety of terms have been used to describe lymphomas with morphological features resembling BL but of uncertain biological linkage; some examples are “small noncleaved,” “non-Burkitt,” “atypical BL,” and “Burkitt-like lymphoma.” Recent studies have shown that BL has a characteristic GEP, but that there are cases within the spectrum of DLBCL with a similar GEP.78–79 Some harbor MYC translocations as a sole abnormality, but others have a more complex karyotype, often with dual translocations affecting MYC and BCL2. These double-hit lymphomas are generally refractory to standard chemotherapy regimens and have a poor prognosis.80–82 In one study using GEP, these cases clustered with BL,78 but in another study, they fell into an intermediate category.79 Therefore, GEP might be useful in the future to identify this subset. The category of B-cell lymphoma, unclassifiable, with features intermediate between DLBCL and BL (B-UNC/BL/DLBCL) was introduced into the WHO classification in large measure to recognize and segregate this prognostically important group.83 (Figure 3) It is likely that the synergistic actions of MYC and BCL2 are responsible for the poor prognosis in these patients, with BCL2 driving an antiapoptotic signal and MYC driving a proliferative signal. The genomic complexity of these tumors might also be responsible for the poor outcome.83
Differential diagnosis of BL, B-UNC/BL/DLBCL, and DLBCL of the GCB type. B-UNC/BL/DLBCL is generally associated with a complex karyotype containing both MYC and BCL2 translocations. BCL2 translocations are found in approximately 30% of the GCB type of DLBCL, but MYC translocation should be absent, and if a dual translocation is found, the case should be classified as B-UNC/BL/DLBCL. Morphologically, BL is composed of medium-sized cells, with minimal nuclear variation. Cell size is largest in DLBCL, and B-UNC/BL/DLBCL is generally composed of cells of intermediate to large size, with greater variability than BL.
Differential diagnosis of BL, B-UNC/BL/DLBCL, and DLBCL of the GCB type. B-UNC/BL/DLBCL is generally associated with a complex karyotype containing both MYC and BCL2 translocations. BCL2 translocations are found in approximately 30% of the GCB type of DLBCL, but MYC translocation should be absent, and if a dual translocation is found, the case should be classified as B-UNC/BL/DLBCL. Morphologically, BL is composed of medium-sized cells, with minimal nuclear variation. Cell size is largest in DLBCL, and B-UNC/BL/DLBCL is generally composed of cells of intermediate to large size, with greater variability than BL.
The precise limits of B-UNC/BL/DLBCL are as yet undefined. However, cases of otherwise typical DLBCL that have a MYC translocation should still be classified as DLBCL. The clinical significance of a MYC translocation in this group is not yet resolved, and may in part depend on the nature of the therapy used. Recent studies have suggested that MYC-positive DLBCLs treated with R-CHOP (rituximab plus cyclophosphamide, hydroxydaunorubicin, oncovin, and prednisone/prednisolone) have a poor prognosis,6,84 but in preliminary data, an adverse effect was not observed in patients treated with DA-EPOCH-R (dose-adjusted etoposide, prednisone, vincristine, cyclophosphamide, and doxorubicin plus rituximab) at the National Cancer Institute.5 In addition, many of the MYC-positive DLBCL in the published series did not have MYC as a sole genetic abnormality.
There is also a subset of DLBCL with a very high proliferation rate approaching 100% and an immunophenotype resembling BL: CD20+, CD10+, BCL-6+, BCL-2−, but lacking a demonstrable MYC translocation. Whether these cases should be classified in the intermediate group or as DLBCL is not yet resolved. At present, our view is to retain these cases within DLBCL. However, the application of immunohistochemical stains for the MYC protein may prove to be useful in such cases, and may identify deregulated MYC expression without a demonstrable MYC translocation. Another ambiguous subset is composed of cases that otherwise would be classified as BL, but exhibit minor cytological variability or weak BCL-2 expression. In the presence of a classical cytogenetic profile, such cases can be retained as BL, and previously were referred to as atypical BL in the third edition of the WHO classification.85 Ongoing studies of cases in this borderland should help to resolve many of these issues in the future.86 Specific histological or immunophenotypic criteria to recognize double-hit lymphomas have not been defined. However, cases negative for the BCL-2 protein are unlikely to carry a BCL2 translocation, and therefore immunohistochemistry for BCL-2 protein may be a useful screening tool short of FISH.82 Histologically, these are generally monomorphic tumors composed of medium to large lymphoid cells, lacking both a starry sky pattern and significant numbers of tumor-infiltrating lymphocytes.
B-UNC/cHL/DLBCL
In recent years, an overlap in biologic and clinical features has been identified among cHL, nodular sclerosis, and PMBL. Further strengthening this relationship is the identification of lymphomas with clinical and morphologic features transitional between the two, also known as GZLs. This category is thought to overlap with what had been termed Hodgkin-like anaplastic large-cell lymphoma in the older literature.87 Most, but not all, of these cases present with mediastinal disease, although in contrast to the parent entities of PMBL and cHL, a male predominance is seen.88
GZLs are composed of pleomorphic tumor cells that sheet out and grow in a diffusely fibrotic stroma. Tumor cells can be reminiscent of PMBL or cHL, with a broad spectrum of cytologic appearances in different areas of the tumor. Clusters of cells similar to lacunar cells or even HRS-cells may be seen in a background resembling PMBL. The inflammatory infiltrate is usually sparse, but scattered eosinophils, lymphocytes, and histiocytes may be present. The immunophenotypic features of GZL are also intermediate, with frequent asynchrony between the morphology and immunophenotype.52 A recent study using methylation profiling also identified an intermediate signature, with differences from both cHL and PMBL.89
The optimal treatment of GZL is not established, and thus far, patients have had a relatively poor outcome with both cHL and NHL regimens.87,90–91 Because they share many of the cytogenetic aberrations seen in cHL and PMBL, a molecular basis for a differential response to therapy is unknown.88 Currently, for CD20-positive GZL, immunochemotherapy with rituximab followed by radiation treatment is a reasonable approach because these patients appear to benefit from a combined modality approach.90
Summary and future outlook
The understanding of aggressive B-cell lymphomas has changed considerably from the days in which most tumors were diagnosed as DLBCL or BL, with few variations. There are now more than 20 clinically and biologically recognized subgroups. The use of high-throughput genomic techniques will continue to add complexity to this picture. Practice guidelines are not yet established regarding the need for ancillary studies in the diagnosis of DLBCL, and will be influenced by how the results will affect therapy. In many clinical practices, R-CHOP with minor modifications is the standard for newly diagnosed patients. However, there is evidence that this regimen is suboptimal for DLBCL harboring a MYC translocation with or without other alterations. In this setting, the routine use of FISH to detect alterations of MYC may be advised. Certainly, ancillary studies are warranted for high-grade tumors for which a diagnosis of BL versus DLBCL must be made. In such cases, both immunohistochemistry and FISH studies are useful to detect double-hit and triple-hit lymphomas, tumors that require more aggressive therapeutic approaches.
The distinction of GCB versus ABC DLBCL has not yet led to differences in primary treatment for most patients. However, for patients with recurrent disease, the choice of therapy is more likely to be influenced by the cell of origin. For example, bortezomib was effective in relapsed ABC DLBCL but not in GCB tumors.92 In addition, the BCR signaling pathway has been shown to be crucial in ABC but not in GCB DLBCL,2 suggesting a potential role for BTK inhibitors in the ABC subset.93 To date, GEP has been restricted to the research laboratory, and has had limited applicability to clinical practice due to the requirement for fresh or snap-frozen tissue. However, newer platforms will permit the translation of this technology to the routine clinical laboratory in the relatively near future, and in conjunction with newer targeted therapies may influence the management of DLCBL in the clinical setting.94–95
Disclosures
Conflict-of-interest disclosures: The authors declare no competing financial interests. Off-label drug use: None disclosed.
Correspondence
Dr Elaine S. Jaffe, Bldg 10/ Rm 2B42, 10 Center Dr MSC-1500, National Institutes of Health, Bethesda, MD 20892-1500; Phone: (301) 496-0184; Fax: (301) 402-2415; e-mail: elainejaffe@nih.gov.